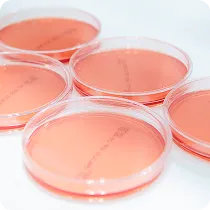
設備・動線・検査体制整備

多くの企業が勘違いしていること
HACCP対応が進まない理由は
“複雑でコストが高いから”ではありません。
-
HACCPを
一気に完成させるものだと思っている - 現場運用と書類整備を分けて考えている
- 日常管理と制度対応を別物として捉えている
補助金を活用すると、
HACCP・衛生強化はここまで進められます
書類設備だけでなく、
工場全体の衛生レベル向上も対象になります。

HACCP構築
- 衛生管理計画の策定
- CCP(重要管理点設定)
- 手順書/記録様式整備

動線改善
- 作業動線の最適化
- ゾーニング設計
- レイアウト改善

衛生設備導入
- 手洗い・殺菌設備
- エアシャワー間仕切り
- 防虫/防鼠対策

衛生検査
- 微生物/拭き取り検査
- 衛生検査体制構築
- 品質管理の仕組み化
分析・設備導入を一環して対応可能!
衛生管理のための導線や設備など
まるっとお任せください!

具体的な取り組み例
- HACCPに基づく衛生管理計画を策定し、手順書・記録様式まで整備
- 店内改装し個室化・設備導入によって、コロナによる感染リスクを低減
- 売上拡大のため包装製品を切り替え、安全に賞味期限を伸ばす設備を導入。
こんなご相談が多くあります
実際には、
次のような
ご相談から検討が始まる
ケースも多くあります。
HACCP対応を求められた
このままで良いか不安
まとめて見直したい

各専門スタッフが
丁寧&スピーディーに対応!
補助金を活用しながら
お悩みを解決します!
補助金を前提にしたHACCP・衛生強化の進め方
-

STEP: 01 現状整理・衛生課題の可視化
補助金を前提に、現場の衛生レベルを整理し、改善すべきポイントを明確にします。やるべきことの優先順位を決め、無理のない改善計画に繋げます。
- 現状衛生レベル確認
- リスク洗い出し
- 改善優先度整理
-

STEP: 02 HACCP構築・運用設計
現場で運用できる形に落とし込むことを重視して、HACCPの仕組みを整備します。計画・記録・手順書を整え、属人化しない運用を目指します。
- 衛生管理計画策定
- CCP設定
- 記録・手順書整備
-
STEP: 03 設備・動線・検査体制整備
運用に必要な設備や動線を整え、衛生レベルを“仕組みとして”底上げします。必要に応じてゾーニングや検査体制まで含めて整備します。
- 動線・ゾーニング改善
- 衛生設備導入
- 検査体制構築
-

STEP: 04 教育・定着/次の展開
HACCPは作って終わりではなく、現場に根付いて初めて意味があります。従業員教育と運用定着を支援し、次の改善につながる体制を作ります。
- 従業員教育
- 運用定着支援
- 次の改善計画
工場衛生化でよく活用される
補助金(一例)
補助金の種類や条件はさまざまですが、
工場自動化では、
以下の制度が使われるケースが多くあります。
-
ものづくり補助金
自動化設備導入・省人化ライン構築など
対象:中小企業・小規模事業者
-
食品産業の輸出向け
HACCP等対応施設整備事業HACCP導入に向けた施設改修や、認証取得のための費用など
対象:輸出拡大を目指す食品製造・流通事業者
※補助金額や補助率は年度や申請枠によって異なる場合があります。
各補助金の詳細な要件については、お問い合わせください。
申請書類・提出は提携の行政書士が実施します。
「補助金コンサルタント」がサポート!
丸信だからできる、
安心の『伴走型支援』



なぜ、丸信なのか
単なる申請代行ではなく、経営者の考えや事業の方向性に沿って、
事業展開や補助金活用の選択肢をご提案します。
-
 POINT
POINT採択実績多数!
食品業界に特化した支援業界課題を理解したスタッフが、貴社の強みを活かす事業計画書を共に作成します。
難易度の高い補助金もお任せください。 -
 POINT
POINT補助金がお客様の手元に
届くまでサポートを継続補助金は「採択後」が重要。煩雑な交付申請や実績報告、行政対応、監査まで、専門スタッフが最後まで徹底フォローします。
-
 POINT
POINT申請サポートに留まらず、
補助金の投資効果を最大化補助金申請だけでなく、事業成長まで見据えた支援が強み。設備導入やEC制作まで、補助金を活かした施策をワンストップでご提案します。
担当紹介
お客様が抱える課題に対して
真摯に向き合い、
挑戦に
伴走する専門家チーム
が在籍しています。

補助金コンサルタント
川見 和嘉 Kawami Kazuyoshi
博士(工学)の学位を持ち、10年以上にわたり補助金申請支援業務に従事。これまでに累計約8億円の補助金採択を支援した実績があります。

補助金コンサルタント
添島 彰 Soejima Akira
自身の会社経営経験を活かし、経営者様と同じ視座でヒアリング。対話の中から「まだ気づいていない強み」や「想定外の活用法」を見つけ出し積極的にご提案します。
補助金を活用して進められるか
確認してみませんか?
構想段階でも問題ありません。
補助金の可否と、
現実的な進め方を整理します。
- 構想段階・アイデアレベルでもOK
- 資料準備は不要
- 無理に進めることはありません



